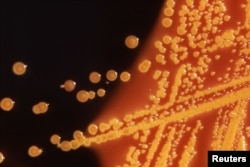

ჯანმო, უკვე წლებია, აცხადებს, რომ ანტიბიოტიკების გაუაზრებელი გამოყენება სწრაფად გვაახლოვებს პოსტანტიბიოტიკურ ეპოქასთან, რომლის დროსაც უმნიშვნელო ტრავმები და მარტივი ინფექციებიც კი შესაძლოა კვლავ სასიკვდილო გახდეს. არსებობს ალტერნატივა? შეუძლიათ თუ არა ბაქტერიოფაგებს, რომელთა წარმოებაში საქართველოს ერთ-ერთი წამყვანი ადგილი უჭირავს, ანტიბიოტიკებს სრულფასოვანი კონკურენცია გაუწიონ?
ანტიბიოტიკორეზისტენტულობა - ეს არის ბაქტერიების მდგრადობა ანტიმიკრობული საშუალებების მიმართ. სხვა სიტყვებით რომ ვთქვათ, ამ შემთხვევაში პრეპარატს ადამიანის განკურნება აღარ შეუძლია. ჯანდაცვის მსოფლიო ორგანიზაციის განცხადებით, ანტიბიოტიკორეზისტენტულობის დონე მსოფლიოში საგანგაშო ზღვარს აღწევს.
„უფრო და უფრო მეტი ინფექცია - მაგალითად, პნევმონია, ტუბერკულოზი, სისხლის ინფექციები, ჰონორეა, საკვებით გამოწვეული დაავადებები - ხდება ძნელად განსაკურნელი, ხანდახან კი საერთოდ შეუძლებელი იმის გამო, რომ ანტიბიოტიკების მოქმედება არაეფექტურია… თუკი ზომები არ მივიღეთ, აღმოვჩნდებით პოსტანტიბიოტიკურ ეპოქაში, რაც ნიშნავს, რომ ინფექციები და უმნიშვნელო ტრავმები ისევ სასიკვდილო გახდება“.
როდის „გამოილევა“ ანტიბიოტიკები?
ის, რომ ბაქტერიებს შეუძლიათ გამოიმუშავონ მდგრადობა, ეს ანტიბიოტიკების მიღებიდან მალევე გახდა ცხადი. ასე მოხდა ჯერ პენიცილინის, შემდეგ კი ამპიცილინის შემთხვევაში, - გვიხსნის მალვინა ჯავახაძე, თბილისის სახელმწიფო სამედიცინო უნივერსიტეტის პროფესორი, ვახტანგ ბოჭორიშვილის სახელობის კლინიკის ინფექციონისტი. - „ჩვენ ცოცხალ არსებებს ვებრძვით. ეს ცოცხალი სამყაროა, რომელიც ჩვენ პირისპირ დგას და მოდუნების საშუალებას არ გვაძლევს. ამიტომ ყოველთვის იყო და დღესაც ძალიან აქტუალურია ახალ-ახალი თაობის ანტიმიკრობული პრეპარატების წარმოება“.
გარდა იმისა, რომ ბაქტერიები თავად “სწავლობენ” ანტიბიოტიკებისგან თავდაცვას, ხშირად ადამიანებიც ეხმარებიან მათ რეზისტენტულობის გამომუშავებაში. მალვინა ჯავახაძე ამბობს, რომ ჩვენ, ექიმებმაც და პაციენტებმაც, “ბევრი შევცოდეთ ამ საქმის გაუარესებაში”. იგულისხმება ანტიბიოტიკების ჭარბი და არასწორი გამოყენება, მაგალითად ანტიბიოტიკებით არა ბაქტერიული, არამედ ვირუსული ინფექციების მკუნალობა.
„ყველა ანტიბიოტიკს თავისი ნიშა უნდა ჰქონდეს. პირველად ჯანდაცვაში სარეზერვო და ფართო სპექტრის ანტიბიოტიკებს არ უნდა იყენებდნენ. პაციენტს, რომელსაც 5 დღე ცხელება, თუნდაც პნევმონია აქვს, ფართო სპექტრის და სარეზერვო ანტიბიოტიკები არ უნდა გაუკეთდეს, რადგან თუ ინფექცია გაურთულდა და სტაციონარში მოხვდა, ექიმი იძულებული გახდება უფრო ძლიერი პრეპარატი დანიშნოს. ღმერთმა ნუ ქნას შემდეგ ინტენსიური თერაპიის განყოფილებაშიც მოხვდეს ეს პაციენტი. ვეღარ გადაარჩენენ, რადგან იმ მიკრობს, რომელმაც ინფექცია გამოიწვია, ყველა სარეზერვო ანტიბიოტიკზე რეზისტენტობა ექნება გამომუშავებული“.
ანტიბიოტიკებს არასწორად იყენებდნენ Covid-19-ის გავრცელების პირველ ეტაპზე. მალვინა ჯავახაძე ჰყვება, რომ ხშირად მათ დაავადების პირველსავე დღეს ნიშნავდნენ.
„კორონავირუსული ინფექციის დროს პირველი 5 დღე ვირუსის აქტივაციის ფაზაა და თუ ამას სერიოზული ბაქტერიული გართულება არ ახლავს (და ასეთი არის მხოლოდ შემთხვევათა 5 %), ანტიბიოტიკი არ უნდა გამოიყენო. პანდემიის დასაწყისში ანტიბიოტიკებს არამიზნობრივად იყენებდნენ, თან - სერიოზულ, ფართო სპექტრის ანტიბაქტერიულ საშუალებებს. ეს, რა თქმა უნდა, პოსტანტიბიოტიკური ეპოქის მოახლოებას დააჩქარებს“.
თუმცა პოსტანტიბიოტიკური ეპოქის მოახლოება შეიძლება გადავადდეს, ერთი მხრივ, ანტიბიოტიკების გონივრული მოხმარების შედეგად, მეორე მხრივ კი, ახალი პრეპარატების გამოგონებით. მაგრამ ახალ მედიკამენტებთან დაკავშირებით მომავალი არცთუ ისე სახარბიელოა.
„თუ წინა ათეულ წლებში, გარკვეულ პერიოდში, 4-5 ანტიბიოტიკი მუშავდებოდა, დღეს უკვე 1-2 ანტიბიოტიკზეა საუბარი. ძველი ანტიბიოტიკები უკვე არ მუშაობს, ახალი კი აღარ გვაქვს“. ინფექციონისტი ამბობს, რომ ამ ყველაფერმა შესაძლოა ერთ დღეს მიგვიყვანოს იმ მომენტამდე, როდესაც ანტიბიოტიკებს მკურნალობის ძალა აღარ ექნებათ. „ეს იქნება მსოფლიო კატასტროფა. პანდემია მასთან შედარებით სახსენებელიც კი არაა“, - ამბობს მალვინა ჯავახაძე.
კარგი ვირუსი, თუ ვინ შეჭამა ცუდი ბაქტერია?
გიორგი ელიავას სახელობის ბაქტერიოფაგიის, მიკრობიოლოგიისა და ვირუსოლოგიის ინსტიტუტში, წლებია, იკვლევენ და “მოჰყავთ” ბაქტერიოფაგები, რომლებიც ნაწილობრივ ანტიბიოტიკების ალტერნატივაა.
ბაქტერიოფაგი არის ვირუსი, უფრო მარტივად რომ ვთქვათ, „კარგი“ ვირუსი, რომელიც „ცუდი“ ბაქტერიით იკვებება. ორგანიზმში მოხვედრისას ფაგი დაავადების გამომწვევ ბაქტერიას პოულობს, არღვევს მის გარსს და შიგნით ათობით ახალ ფაგს წარმოქმნის. ბაქტერიის განადგურების შემდეგ ახალი ფაგები სხვა „ცუდი“ ბაქტერიების მოსახელთებლად ორგანიზმში „მოგზაურობას“ იწყებენ, ხოლო როდესაც მისია დასრულდება, ორგანიზმს ტოვებენ.
პირველი, ვინც ბაქტერიოფაგების მეშვეობით ადამიანის განკურნება შეძლო, კანადელი მეცნიერი ფელიქს დ’ერელი იყო. 1919 წელს მან 12 წლის ბავშვი დიზენტერიისგან მოარჩინა.
ამ ამბიდან ორი წლის შემდეგ საფრანგეთში დ’ერელი ქართველმა მიკრობიოლოგმა, გიორგი ელიავამ, გაიცნო.
„ელიავა ძალიან დაინტერესდა ამ თემით. გადაწყვიტეს ამ მიმართულებით კვლევები ჩაეტარებინათ. შემდეგ ელიავამ დ’ერელი საქართველოში ჩამოიყვანა, თბილისში ბაქტერიოფაგების შესწავლისა და გამოყენების მსოფლიო ცენტრი უნდა შეექმნათ. აქედან დაიწყო ყველაფერი.
“1923 წელს [საქართველოში] ინსტიტუტი გაიხსნა“, - ჰყვება მზია ქუთათელაძე, დირექტორი ინსტიტუტისა, რომელიც დღეს გიორგი ელიავას სახელს ატარებს.
თუმცა ყოველთვის ასე არ იყო. 30-იანი წლების ბოლოს ელიავა პოლიტიკური რეპრესიების მსხვერპლი გახდა. ის დახვრიტეს. დიდი ხნის განმავლობაში ცდილობდნენ გიორგი ელიავა ინსტიტუტის ისტორიიდან ამოეშალათ. მისი სახელი გულმოდგინედ ამოშალეს დოკუმენტებზე, რომლებიც ახლა ინსტიტუტის არქივში ინახება. ამ მოვლენების შემდეგ დ’ერელი თბილისში აღარ დაბრუნებულა.
დასავლეთისგან დავიწყებული
იმ პერიოდში ფაგებს აქტიურად იყენებდნენ საფრანგეთში, გერმანიასა და ამერიკაში. ინდოეთში ფაგებით მკურნალობდნენ ქოლერას. ასე გაგრძელდა 40-იან წლებამდე, მერე კი ბაქტერიული დაავადებების მკურნალობაში პირველი ადგილი ანტიბიოტიკებმა დაიკავეს. ამის შემდეგ დასავლეთმა ბაქტერიოფაგები ნელ-ნელა დაივიწყა. საქართველოში ელიავას ინსტიტუტი ფაგების წარმოებასა და შესწავლას კვლავ განაგრძობდა, თუმცა ყოფილი საბჭოთა კავშირის მიღმა ფაგები, როგორც მედიკამენტები, არ არის დარეგისტრირებული და პრაქტიკულად არ გამოიყენება.
„რატომ არ არის აღიარებული საზღვარგარეთ? იმიტომ რომ სათანადო დონეზე არ ჩატარებულა ფაგების ე. წ. ორმაგი ბრმა კვლევები (double blind). აშშ-ის საკვებისა და წამლების ადმინისტრაციას (FDA) ფაგები თერაპიული გამოყენებისთვის ჯერ არ უღიარებია, მხოლოდ ინდივიდუალური გამოყენებაა დასაშვები. ბელგიელები არიან ძალიან აქტიურები ამ მიმართულებით. ბელგიის ჯანდაცვის სამინისტრომაც გასცა ნებართვა იმაზე, რომ ინდივიდუალურად პაციენტებს ფაგებით უმკურნალონ. საფრანგეთშიც რაღაც აქტივობებია, გერმანიაში რამდენიმე კლინიკური კვლევა მიმდინარეობს...“ - ამბობს მზია ქუთათელაძე.
მისი თქმით, სწორედ ამის გამო ბევრი უცხოელი თბილისში ჩამოდის ფაგებით სამკურნალოდ. უმეტესობა ანტიბიოტიკების ალტერნატივას ეძებს.
„არაფერი მოქმედებს და მხოლოდ ფაგია მათთვის გადარჩენის საშუალება. აი, ახლაც მომივიდა წერილი ინგლისიდან, სადაც ჩვენ ფაგები გვქონდა გაგზავნილი და შვიდ ადამიანს ამპუტაციისგან გადავურჩინეთ დიაბეტური წყლულით დაავადებული ფეხი“
ფაგებს ანტიბიოტიკებთან შედარებით კიდევ ერთი უპირატესობა აქვთ. ორგანიზმში მოხვედრილი ანტიბიოტიკი ბომბივით მოქმედებს, ის „კარგ“ ბაქტერიებსაც ანადგურებს და „ცუდებსაც“, ფაგები კი, სნაიპერებივით, დამიზნებით, მხოლოდ „ცუდებს“ ესვრიან.
„უცხოელების 90% მოდის ქრონიკული დაავადებებით. ეს არის, მაგალითად, მუსკოვისციდოზი, კისტოზური ფიბროზი, რომელიც გენეტიკური დაავადებაა. ასევე არის საჭმლის მომნელებელი სისტემის დაავადებები, რომლებიც წლების განმავლობაში გრძელდება. მათ სისტემატურად უნდა მიეცეთ რაღაც ანტიბაქტერიული საშუალება. ფაგი ამ შემთხვევაში ძალიან კარგია“, - ამბობს მზია ქუთათელაძე.
- შეიძლება ფაგებმა სრულად ჩაანაცვლონ ანტიბიოტიკები?
„ გამორიცხულია. ფაგი სრულად ვერ შეცვლის ანტიბიოტიკს, ამას ჩვენ არ ვამბობთ. ეს [ბაქტერიოფაგები] არ არის პანაცეა, რომ ყველა ბაქტერიულ დაავადებას ფაგებით ვუმკურნალოთ, არა“, - ამბობს მზია ქუთათელაძე.